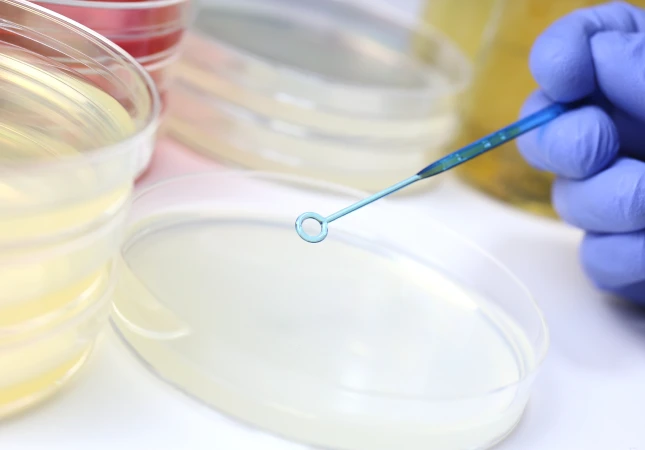

食品検査サービス


消費者へ安心・安全な
食品の品質管理に関する様々なニーズにお応えする、専門的な検査サービスをご提供しております。
お客様の製品の安全性確保、品質向上、そして消費者からの信頼獲得を全面的にサポートいたします。
検査項目
栄養成分表示の食品カロリー検査を行います。
2015年4月1日に食品表示法が施行され、容器包装に入れられた加工食品及び添加物は栄養成分を表示することが原則として義務化されています。この表示について、検査・分析を行い正しいデータを提供いたします。
| 食品表示基準に 既定される成分 | 加工食品 | 生鮮食品 | 添加物 | |||
| 一般 | 業務 | 一般 | 業務 | 一般 | 業務 | |
| 基本5項目 熱量・たんぱく質・ 脂質・食塩相当量 (ナトリウム) | 義務 | 任意 | 任意 | 任意 | 義務 | 任意 |

分析方法
メリット:最終食品を測定する事で調理法、生産地等カロリー変動に左右されないほか、測定期間が短く安価で測定可能
デメリット:黒色の食品など測定できない食品がある
表示例:『この表示値は、目安です。』『推定値』
メリット:食品表示基準別表第9の第3欄に掲げる方法であり強調表示に使用できる
デメリット:分析期間が長くコストが高価
表示例:『分析値』 ※許容差の範囲を外れる可能性のある場合『分析値』とは記載できません。
検査費用
| 検査項目 | 分析方法 | 検査期間 | 費用 |
| 【義務5項目】 熱量・たんぱく質・脂質・炭水化物・食塩相当量(ナトリウム) | 近赤外分光法 | 1週間 | 8,140円(税込) |
| 【義務5項目】 熱量・たんぱく質・脂質・炭水化物・食塩相当量(ナトリウム) | 公定法 | 2 週間 | 19,250円(税込) |
| 【義務5項目+推奨2項目】 熱量・たんぱく質・脂質・炭水化物・食塩相当量(ナトリウム)・食物繊維・糖質 | 公定法 | 3 週間 | お問合せください |
※近赤外分光法は検査のできない食品もございます。詳しくはお問合わせ下さい。(例:黒い食品、サプリメント、アルコール入り食品、難消化性糖類や食物繊維を多く含む食品など)
※追加分析項目についてはフォームからお問い合わせください。
※指定の検査センターに保存方法と同等条件で発送してください。
※平日に到着するようにお送りください。
※検体全量を発送してください。(1検体が100g未満の場合は複数個の発送をお願いします。)
※検査期間は検体到着後からの日数となります。
※セット品や固形と汁物が合わさった食品に対しては数回に分けて検査を行う場合がございます。その場合、回数分の費用が発生致しますので、事前にご相談させていただきます。
※おせち料理につきましては、1段に付き1検体とさせていただいております。また、オードブルなど品目が多いものについては、追加費用が発生する場合がございます。
※提出された検体・容器は、受付時に返却を求められない限り破棄致します。
※近赤外分光法は、簡易栄養成分測定器での機械測定です。
検査結果の数値に疑義が生じた場合、弊社は、返金もしくは再検査の限りにおいて対応させていただくものとし、
その他一切の法的責任を負わないものとします。なお、再検査のための検体の送付はお客様負担でお願いいたします。
お客様が検査結果を利用したことに起因して被った損害等に関して、弊社は一切の法的責任を負いかねますので、予めご了承ください。
検査の流れ
入金確認後、検査スケジュールを打ち合わせさせて頂きます。
(1検体が100g未満の場合は複数個の発送をお願いします。)
原本郵送をご希望される方は、お申し込みの際に「原本郵送を希望する」にチェックを入れてください。
品質管理、消費期限・賞味期限の設定の
参考検査を行います。
食品の腐敗や劣化、食中毒を引き起こす要因は、微生物の付着・混入・増殖です。そのため、消費者に安全な食品を提供するには、食品中における微生物の状況を検査する衛生指標菌の検査を行うことが重要になります。
これにより、品質評価、安全性評価の指標とすることができます。
検査対象:弁当 / 惣菜 / 洋菓子 / 乳製品 / アイスクリーム類 / 氷雪 / 氷菓 / 魚肉ねり製品 / 冷凍食品 / 食肉食品など

消費期限・賞味期限について
加工食品は消費期限または賞味期限のどちらか一方のみの表示が義務づけられております。賞味期限はスナック菓子・カップ麺・缶詰など比較的劣化が遅い食品に表示し、消費期限は弁当・惣菜・調理パンなど、急速に劣化する食品や傷みやすい表示されています。
適切な賞味期限設定をするためには、食品の特性に配慮した上で、客観的な指標(理化学試験・微生物試験・官能検査など)から得られた期限に対して、1未満の係数(安全係数)をかけて設定することが基本とされています。
弊社では、農林水産省・厚生労働省のガイドラインに基づき、設定したい賞味期限をお客様にお伺いし、その期限に安全係数を加味した日数の日程に食品細菌検査による保存試験を実施するサポートを致します。

主な検査項目
一般生菌数は食品全般の衛生的な取扱いの指標となります。一般生菌が多いと食中毒のリスクが高まります。
大腸菌をはじめ、多くの腸内細菌科が含まれ、検出された場合、二次感染の可能性があります。
黄色ブドウ球菌が食品の中で増殖するとき毒素をつくり、この毒素を食品と一緒に食べることにより人に危害を及ぼす可能性があります。
検査費用
| 検査項目 | 検査期間 | 費用 |
| 食品細菌検査:一般生菌・大腸菌群・黄色ブドウ球菌検査セット | 1週間 | 6,600円(税込) |
※検査期間は1週間です。
※平日に到着するようにお送りください。
※配送方法は必ず保管温度と同じ状態でお送りください。
検査の流れ
入金確認後、検査スケジュールを打ち合わせさせて頂きます。
原本郵送をご希望される方は、お申し込みの際に「原本郵送を希望する」にチェックを入れてください。
食中毒保菌者の早期発見、
二次感染を防ぐための検査を行います。
腸内に菌がいることに気付かず調理等に携わることで、大きな食中毒事故になる可能性があります。そのため、腸内細菌検査は大量調理施設衛生管理マニュアル、学校食品衛生管理基準など食品を取扱う事業者は製造、加工、調理、販売の従事者の健康管理や腸内細菌検査の実施に努める必要があると記載されています。腸内細菌検便検査は健康保菌者を把握することで食中毒の発生を防止します。
検査対象:飲食店 / 食品工場 / 幼稚園や保育園 / 公立·私立学校 / ホテル·旅館 / 介護施設 / 水道関係の会社など
検査項目
- 測定3項目:赤痢菌、サルモネラ属菌、大腸菌O157
- 測定5項目:赤痢菌、サルモネラ属菌、大腸菌Oー157, Oー111, Oー26
- 測定項目:腸管出血性大腸菌全菌
- 測定項目:コレラ菌
- 測定項目:腸炎ビブリオ
- 測定項目:カンピロバクター
検査費用
検査対象者数、検査回数、検査項目により金額が異なります。フォームからお問い合わせください。
検査の流れ
入金確認後、検査スケジュールを打ち合わせさせて頂きます。
対象者名簿をお客様の方で作成していただき、ご提出をお願いしています。
※ノロウイルス検査・海外帰国者向け細菌検査と合せて発送する場合は、クール便(冷蔵)で発送して頂いても構いません。
原本郵送をご希望される方は、お申し込みの際に「原本郵送を希望する」にチェックを入れてください。
陽性の場合は電話もしくはメールで検査終了後直ちにご連絡いたします。
ノロウイルス保菌者の早期発見、
二次感染を防ぐための検査を行います。
食品の腐敗や劣化、食中毒を引き起こす要因は、微生物の付着・混入・増殖です。そのため、消費者に安全な食品を提供するには、食品中における微生物の状況を検査する衛生指標菌の検査を行うことが重要になります。
これにより、品質評価、安全性評価の指標とすることができます。
検査対象:弁当 / 惣菜 / 洋菓子 / 乳製品 / アイスクリーム類 / 氷雪 / 氷菓 / 魚肉ねり製品 / 冷凍食品 / 食肉食品など


特急便ノロウイルス検査は
到着翌日中に検査結果が分かります
ノロウイルスは非常に感染力が強く乾燥にも強いことが知られ、特に頻発する10月~3月には食中毒事故の予防の一つとして、食品取扱者のウイルス性胃腸炎の感染有無を把握しておくことが非常に重要となっています。そのため、『大量調理施設衛生管理マニュアル』には、ノロウイルス検査の必要性が記載されています。
特急便ノロウイルス検便検査のメリット
食品製造・販売を行う施設でノロウイルス感染が発生した際、二次感染により大きな集団発生へとつながる可能性があります。
ノロウイルスは少ないウイルス量でヒトに感染するので、感染者のごくわずかなおう吐物が付着した食品でも多くのヒトを発症させてしまいます。食品製造現場で起こった嘔吐や体調不良の原因を早急に確認する必要があります。ノロウイルス感染者が発生した場合、最初に取る対応が後の感染拡大予防に大きく影響するため、最初の対応については迅速・適切に実施することが重要です。
検査結果を早く把握することは感染拡大の防止対策に重要な情報となります。
当社のノロウイルス検査は検体到着後、翌営業日に検査結果をご報告いたします。

検査方法
簡易法(EIA/イムノクロマト)と比べてリアルタイムPCR法・ BLEIA法はウイルス濃度範囲が広く、無症状患者の便からの10⁵オーダーの微量なウイルスの検査が可能です。検査結果をもとに適切な安全処置をとることができます。
検査費用
| 検査項目 | 検査期間 | 費用 |
| 特急便ノロウイルス検便検査 | 検体到着後、翌日営業 | 5,500円(税込) |
| 定期ノロウイルス検便検査 | 4日 | お問合せください |
※検査期間は1週間です。
※指定の検査センターに冷蔵便でお送りください。
※平日に到着するようにお送りください。
※配送方法は必ず保管温度と同じ状態でお送りください。
検査の流れ
入金確認後、検査スケジュールを打ち合わせさせて頂きます。
対象者名簿をお客様の方で作成していただき、ご提出をお願いしています。
原本郵送をご希望される方は、お申し込みの際に「原本郵送を希望する」にチェックを入れてください。
陽性の場合は電話もしくはメールで検査終了後直ちにご連絡いたします。
見えない菌を見える化するための検査
細菌は肉眼では見ることができず、たとえ見た目がきれいであったとしても多数の細菌が残存していることがあります。また、洗い残した食品残渣があれば、そこに付着した細菌などが猛烈に増殖(例:大腸菌は6時間で262,144個)し、食中毒菌を10万個以上摂取すると食中毒症状が出る可能性があります。
洗浄・消毒がマニュアルどおりに正しく実施され、清浄度が確保されているか否かを科学的手法により検証するのがふき取り検査です。
汚染度、洗浄度が数値により確認することで「どこに汚染菌がいるか?どの菌がいるか?」など衛生管理に重要な情報を得ることができます。

主な検査項目
一般生菌は食品の衛生学的品質を評価する衛生指標菌とされています。細菌の種類にかかわらず、どの程度“生きた細菌”がいたのかを示すものです。環境中のすべての細菌が検出され、その環境にどの程度の濃度で細菌がいるのかを意味します。
大腸菌・大腸菌群検査は食品の衛生指標菌として非常に重要な検査です。食品が衛生的に取り扱われたか否かを判断する情報となったり、食品の種類によっては可食の判断情報となります。
黄色ブドウ球菌はヒトの常在菌としても存在しており、健康な人の20〜30%が保菌していると言われています。食品中で増殖すると毒素を産生し、この毒素により食中毒を起こします。加工原料だけではなく、各加工段階での黄色ブドウ球菌汚染を防ぐことが重要となっております。
検査費用
| 検査項目 | 検査期間 | 費用 |
| 一般生菌検査 5箇所 | 1週間 | 7,700円(税込) |
| 一般生菌・大腸菌群・黄色ブドウ球菌検査 5箇所 | 2 週間 | 17,050円(税込) |
※検査期間は1週間です。
※追加ふき取り箇所、検査項目についてはフォームからお問い合わせください。
※ふき取り後は速やかに指定の検査センターに冷蔵便でお送りください。
※平日に到着するようにお送りください。
※検査期間は検体到着後からの日数となります。
検査の流れ
入金確認後、検査スケジュールを打ち合わせさせて頂きます。
検査方法はこちら[PDF] >
原本郵送をご希望される方は、お申し込みの際に「原本郵送を希望する」にチェックを入れてください。
商品案内
衛生用品
- 大容量
カヤクリーンYM商品コード:10140699
内容量:5kg
ケース入数:3力強い洗浄力と強力な除菌効果(第4級アンモニウム塩系)を持たせた洗浄除菌剤。泡立ちが良くしつこい油汚れを軽快に洗い落とし素早く洗い上げるので除菌効果もアップ。各種の微生物に対して優れた除菌効果を発揮。50-200倍希釈 - 軽減税率対象
ギャザコールCS商品コード:10323155
内容量:5L
ケース入数:4食品に付着した細菌の除菌、または水分を多く含んだ(まな板)などの厨房器具に優れた除菌効果を得れるように開発されたアルコール製剤。 - 軽減税率対象
フォルテクターⅡ ガン付商品コード:10313866
内容量:500ml
ケース入数:12サラッとした使用感でアルコール特有の刺激臭を軽減し金属腐食性を改善したアルコール製剤。コンパクトで持ち易い製品。 - 大容量軽減税率対象
ラトナールV63商品コード:10223117
内容量:1L
ケース入数:8独自の配合でノロウイルス対策用に開発されたアルコール製剤で、厨房機器・器具、施設のあらゆる場所で幅広く使用可能。1Lポンプタイプで各ポジションに設置可能。 - 大容量軽減税率対象
MY-75商品コード:10163812
内容量:5L
ケース入数:475度の一般的なアルコール製剤。食品添加物のため、食品にも添加可能。 - 大容量軽減税率対象
MY-65商品コード:10291504
内容量:18kg
ケース入数:165度の一般的なアルコール製剤。食品添加物のため、食品にも添加可能。 - 大容量軽減税率対象
アルコリジンNeo商品コード:10280919
内容量:20L
ケース入数:1ポリリジンを含んだアルコール製剤。容器、器具などの表面に噴霧して除菌。濡れた所でも除菌効果大。 - 希釈ボトル
マイソフトコンク商品コード:10215273
内容量:1kg
ケース入数:4パウチタイプで環境とコストを両立。コンパクトで省スペース。4袋で通常の洗剤一斗缶1本分(18kg)の使い出がある。 - 大容量希釈ボトル
Nスター薬用ハンドウォッシュ VA商品コード:10357430
内容量:5kg
ケース入数:3パウチタイプのためコンパクトで省スペース。5~10倍に薄めて使えるので経済的。
フォームディスペンサー
商品コード:10323257
内容量:500ml
ケース入数:6ハンドソープ専用のディスペンサー。泡状になるので石けん液を泡立てる手間を省ける。- 大容量
Nスター商品コード:10315130
内容量:1L
ケース入数:12手指消毒用アルコール。洗浄に除菌・ウイルス除去効果をプラスする事で、より効果的なウイルス対策が出来ます。
NoRostar VGクリーナー商品コード:10357431
内容量:4kg
ケース入数:4ノンアルコール処方の拭き掃除用。薬剤などが効きにくいノンエンベローブウイルスに対しても高いウイルス除去効果があります。原液で使用- 軽減税率対象
ノロスター商品コード:10291513
内容量:5kg
ケース入数:4洗浄に除菌・ウイルス除去効果をプラスする事で、より効果的なウイルス対策が出来ます。
NoRostar トイレクリーナー商品コード:10357432
内容量:2.5kg
ケース入数:6さっとふくだけで洗浄、ウイルス除去、除菌、消臭ができます。二度ぶきいらずで、作業性アップ。ニオイの元となる菌を退治します。便器だけでなく、鏡、洗面台にも使えます(原液で使用)- 大容量軽減税率対象
ウォッシュLB商品コード:10343168
内容量:18kg
ケース入数:1野菜類、魚介類の食品用洗浄剤。次亜塩素ナトリウムとの併用で除菌効果向上
日持向上・品質保持剤
- 軽減税率対象
M-109商品コード:10318674
内容量:1kg
ケース入数:10日持向上目的で使用する酢酸ナトリウム、εーポリリジン製剤(粉末)
ポリリジンは天然系の既存添加物の代表的な保存料。
ポリリジン配合により、一般生菌、枯草菌はもとより、乳酸菌、酵母の増殖抑制に強い効果を発揮。 - 軽減税率対象
マイキープC商品コード:10169882
内容量:12kg
ケース入数:1日持向上目的で使用する酢酸ナトリウム、グリシン製剤(粉末)
味覚への影響が出にくい工夫がされており惣菜全般に使用可能。 - 軽減税率対象
トップキーピングデリRC商品コード:10210729
内容量:20kg
ケース入数:1米飯用の制菌剤。味飯に最適で味覚を損なうことなく日持ち向上。 - 軽減税率対象
トップビストロフローズンR商品コード:10347418
内容量:1kg
ケース入数:10冷凍米飯用の品質改良剤
・白蝋化を抑制
・粘りの低下を防ぎ、解凍後もぼそつきの少ない自然な食感
・酵素と高保水性食品素材によって安定した効果を発揮 - 軽減税率対象
トップキーピングNo.9商品コード:10241548
内容量:20L
ケース入数:1酸味酸臭の少ない醸造酢。米飯(白飯、味飯)の保存性を向上させる。 - 軽減税率対象
トップキープSUD商品コード:10323258
内容量:10kg
ケース入数:1パン類、洋菓子、中華まんじゅうなどの日持ち向上。
主成分はグリシンで耐熱性菌に効果あり。酢酸ナトリウム不使用。 - 軽減税率対象
トップキープデリMP商品コード:10290461
内容量:10kg
ケース入数:1蒸しパンなどの日持ちしにくいものにも効果あり。耐熱性菌以外に酵母、乳酸菌にも効果があり、酸味を抑えた味覚への影響が少ない制菌剤。 - 軽減税率対象
トップベジエース鮮菜緑商品コード:10323259
内容量:10kg
ケース入数:1カット野菜の除菌と保存性向上。色調と食感も維持。味への影響が少ない。 - 大容量軽減税率対象
ピアコリンSP商品コード:10334214
内容量:1kg
ケース入数:12カット果実の風味向上と品質保持。アセロラ果汁とその他の有効成分により良質な品質が得られる。バナナ、リンゴ、ナシ根菜類に使用可能。 - 大容量軽減税率対象
グループB商品コード:10291731
内容量:10kg
ケース入数:1鮮度保持とカビの抑制に効果あり。メロン、マンゴー、ブルーベリーなどにも使用可能。
よくあるご質問
ホームページからの受付のみとさせていただきます。
申し込み内容の誤りを防止するため、何卒ご理解のほどよろしくお願いいたします。
送料につきましては、恐れ入りますがお客様にてご負担をいただきますよう、お願いいたします。
ふき取り検査の予備キットの発送は行っておりません。
ノロウイルス検査・海外帰国者向け細菌検査・腸内細菌検査は、検査人数に応じて、予備キットをご用意いたします。
ご注文確認後、検査確認書を弊社より送付いたします。
検査内容をご確認頂き、お客様からのご返信が確認出来次第、検査キットを発送いたします。
発送時期については確定後に追ってご案内いたします。
営業時間は平日8:30〜12:00/13:00〜17:00です。
土曜日・日曜日・祝日は休業日です。
年末年始休業、ゴールデンウイーク休業、夏季休業がございます。
営業時間外のお申込み・お問い合わせは、翌営業日に対応いたします。
検査の種別やエリアによって発送先検査会社が異なります。
お申込受付の際に検査を担当する検査会社をご案内いたします。
また受付前の検体は受け取りできないため、まずはお申込からお願いいたします。
希望納期については一度ご相談ください。
検査の種別によって必要な日数がございます。
なるべく日程に余裕を持ってお申込くださいませ。
食品細菌検査で、賞味期限設定のための参考検査が可能です。
まずは管轄の保健所の方へ企画をされている食品の衛生基準や必要な検査項目についてお問い合わせください。
製造者(輸入者)責任の観点から、原則お客様の方でご確認いただいて検査の内容をご指定いただいております。
義務5項目以外の分析も可能です。
ご希望される項目をご連絡ください。
対応の可否の回答と共に見積をご案内いたします。
検査のご依頼・お問い合わせ
食品検査サービスに関する検査のご依頼やお問い合わせについては、以下のボタンをクリックし進んだ先の専用フォームよりご連絡をお願いいたします。